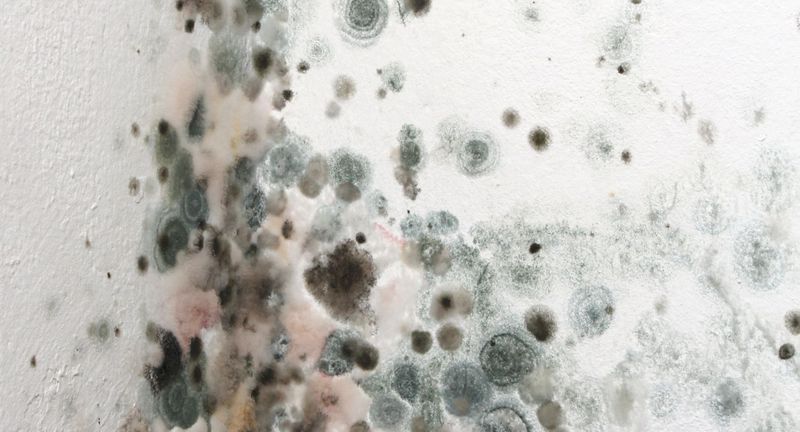
mold on a wall

Blog
Recent Updates
The Importance of Professional Debris Removal After Disasters
Prolonged downtime after a disaster is a direct threat to any company’s bottom line. Strategic Global Resources provides the industrial-grade debris removal services necessary to accelerate your reconstruction timeline. By deploying heavy machinery and expert crews, we clear the wreckage rapidly and safely, ensuring your organization transitions from crisis management to active rebuilding in record time.
moreEssential Tools Every Restoration Company Should Consider Renting
When disaster strikes across the southeast, the scale of recovery can quickly outpace your available inventory. Maintaining a massive fleet of specialized machinery is costly and often impractical for every scenario. Strategic Global Resources understands that renting allows your restoration company to scale rapidly, access cutting-edge technology, and handle complex commercial projects without the heavy burden of maintenance.
moreThe Critical Role of Dehumidification in Preventing Mold After a Disaster
In the chaotic aftermath of a disaster, moisture is your silent enemy. While standing water is the obvious threat, lingering high humidity triggers rapid mold growth within forty-eight hours. At Strategic Global Resources, we prioritize advanced dehumidification to stabilize your environment, ensuring your recovery process is safe, efficient, and free from secondary structural damage.
moreThe Value of Renting vs. Buying Disaster Recovery Equipment
When disaster strikes, your response speed determines your recovery success. For many restoration contractors and facility managers, the toughest decision isn't how to clean up, but whether to own or rent the heavy-duty fleet required. At Strategic Global Resources, serving the Southeast, we believe flexibility is the ultimate asset when navigating the unpredictable nature of large-scale recovery projects.
moreWinterization: Proactive Heating Strategies for Jobsite Safety
As temperatures plummet, construction and industrial jobsites face a unique set of hazards that can compromise both structural integrity and personnel safety. Winterization is not merely a seasonal convenience; it is a critical safety protocol. Strategic Global Resources provides high-performance heating solutions designed to combat the brutal effects of cold weather. By implementing a proactive heating strategy, project managers can prevent frozen infrastructure, ensure material performance, and, most importantly, protect the health and well-being of their workforce during the winter months.
moreSolving Labor Shortages with On-Site Temporary Housing
The modern industrial landscape is facing a significant hurdle: a shrinking pool of skilled labor, particularly in remote or disaster-stricken areas. When projects are located far from urban centers, the lack of local housing becomes a primary barrier to recruitment. Strategic Global Resources addresses this challenge by providing turnkey, on-site temporary housing solutions. By bringing the accommodations to the job site, companies can attract top-tier talent from across the country, ensuring that critical projects remain on schedule and fully staffed.
moreClimate Control: Protecting High-End Interior Finishes
Luxury construction and high-end renovations require more than just skilled craftsmanship; they demand a strictly regulated environment. High-value materials such as exotic hardwoods, custom millwork, and delicate wall coverings are highly sensitive to atmospheric changes. Strategic Global Resources provides specialized climate control solutions that safeguard these investments, ensuring that premium interior finishes are installed and maintained under optimal conditions to prevent irreversible structural or aesthetic damage.
moreHow Reefer Rentals Prevent Costly Inventory Loss
In the fast-paced world of logistics, maintaining temperature integrity is not just a preference—it is a financial necessity. For businesses dealing with perishables, pharmaceuticals, or sensitive chemicals, a minor fluctuation in climate can result in catastrophic financial deficits. Strategic Global Resources provides advanced reefer rentals designed to mitigate these risks, offering a reliable safeguard against the unpredictable variables of supply chain management and equipment failure.
moreThe Importance of Reliable Temporary Power in Disaster Recovery
When disaster hits, a sudden and total loss of power can halt recovery efforts before they even begin. At Strategic Global Resources, we understand that time is the most valuable commodity in these critical moments. That is why having immediate, reliable access to robust temporary power solutions is not just an advantage—it is a non-negotiable foundation for effective disaster recovery and restoration. Our goal is to ensure your project is powered safely and efficiently from the very first hour.
moreEssential Construction Equipment Rentals for Disaster Restoration
When a disaster strikes, the immediate aftermath is defined by two things: urgency and complexity. For every restoration contractor, having swift access to the right tools is not just helpful—it’s absolutely essential. At Strategic Global Resources, we understand that recovery is a race against time, which is why we specialize in providing turnkey solutions for construction equipment rental in Memphis. Our reliable, commercial-grade heavy machinery rental in Memphis helps teams tackle debris, stabilize structures, and begin the critical work of rebuilding quickly and safely.
moreFAQs on Dehumidification and Climate Control Rentals
When dealing with disaster recovery, construction, or even localized facility maintenance, climate control is often the unsung hero that ensures success. Excess moisture and extreme temperatures can jeopardize both structure and timeline. At Strategic Global Resources, we understand the critical nature of these environments. Our team specializes in providing the dehumidification equipment in Memphis, offering comprehensive, temporary solutions to control your operational climate precisely.
moreHow SGR Supports Restoration Companies in Times of Crisis
In disaster recovery, speed and the right tools are non-negotiable keys to success. As Strategic Global Resources (SGR), we know restoration companies are under immense pressure to stabilize sites quickly and begin returning properties to pre-loss condition. Our role is to be the critical infrastructure partner that makes your immediate and long-term recovery efforts—like fire restoration and flood restoration—possible. We equip your team with unparalleled support and restoration equipment rentals in Memphis.
moreHow Local Logistics Speed Up Disaster Cleanup in Memphis
Time is the single most valuable commodity in the chaotic wake of a disaster. While national providers may eventually arrive, the most critical window for recovery and mitigating further damage demands immediate action from a local partner. For any major disaster cleanup in Memphis and the surrounding area, having a strategically positioned logistics hub is the key to minimizing downtime. At Strategic Global Resources, our geographic location and established regional networks allow us to deploy resources faster than anyone else, fundamentally accelerating the entire recovery timeline for governmental agencies and prime contractors.
moreWhy Advanced Construction Site Security in Memphis is Non-Negotiable
In the dynamic world of construction in Memphis, job site security is not merely a formality; it is a critical safeguard for multi-million dollar investments. The risk of asset theft, vandalism, and unauthorized access is constant, creating serious threats to project timelines and budget stability. At Strategic Global Resources, we provide comprehensive, proactive solutions, ensuring your valuable equipment and materials are protected from day one.
moreStay Cool and Functional: Why You Need a Temporary AC Unit Rental in Memphis
In the humid heat of Memphis, a malfunctioning HVAC system or the absence of climate control on a job site can halt operations, spoil materials, and compromise occupant safety instantly. At Strategic Global Resources, we recognize that rapid deployment of temporary cooling is not a luxury—it is a critical necessity for maintaining project timelines and worker comfort. Our commitment is to deliver comprehensive and energy-efficient temporary ac unit rentals in Memphis swiftly, ensuring your business environment remains functional, safe, and optimally regulated, no matter the situation.
moreThe Memphis Difference: Essential Equipment for Water Damage Restoration
When water damage strikes a property in Memphis, acting quickly with professional-grade equipment is the only way to mitigate long-term structural issues and prevent secondary damage like mold. At Strategic Global Resources, we understand that a fast, effective response is paramount for our clients. That is why our extensive inventory is stocked with the precise tools necessary for thorough structural drying and successful property restoration.
more4 Reasons to Leave Debris Removal to the Professionals
After a major weather event, the cleanup can seem overwhelming, but tackling it alone can be a mistake. At Strategic Global Resources, we want to ensure your recovery is handled correctly from the start. Explore why relying on a professional team for debris removal is the most effective and safest decision you can make.
more4 Essential Steps for a Flawless Temporary Power Setup
Ensuring your project or event has reliable electricity is non-negotiable. A seamless setup depends on expertly planned temporary power and distribution solutions tailored to your specific needs. Discover how our team at Strategic Global Resources ensures your operation is powered for success.
moreA Closer Look at SGR's Comprehensive Debris Removal Services
Following a disaster, the path to recovery begins with a swift and organized cleanup effort. At Strategic Global Resources, we provide comprehensive debris removal services designed to handle every aspect of the post-event environment efficiently and safely.
moreA Guide to Effective Emergency Preparedness Planning
Effective emergency preparedness planning is the cornerstone of a resilient and secure community. At Strategic Global Resources, we understand the critical nature of having a robust strategy in place before a crisis strikes. Let our guide help you begin this essential process today.
moreWhy Temporary Housing is Essential for Disaster Recovery Teams
In the wake of a disaster, providing immediate support to affected communities requires dedicated teams of restoration professionals. At Strategic Global Resources (SGR), we understand that having reliable temporary housing is crucial for these teams to operate effectively. Here’s why temporary housing should be a priority for disaster recovery efforts.
moreWhy Restoration Companies Should Choose SGR for Disaster Recovery Equipment Rentals
When disaster strikes, restoration companies need reliable partners to support their recovery efforts. At Strategic Global Resources (SGR), we specialize in disaster recovery equipment rentals in Memphis, offering a wide range of solutions tailored to meet the unique needs of restoration professionals. Here’s why choosing us as your equipment rental partner is the right decision for your disaster recovery and restoration projects.
moreWelcome
Welcome to our site! We are in the process of building our blog page and will have many interesting articles to share in the coming months. Please stay tuned to this page for information to come. And if you have any questions about our business or want to reach out to us, we would love for you to stop by our contact page.
Thank you!
more